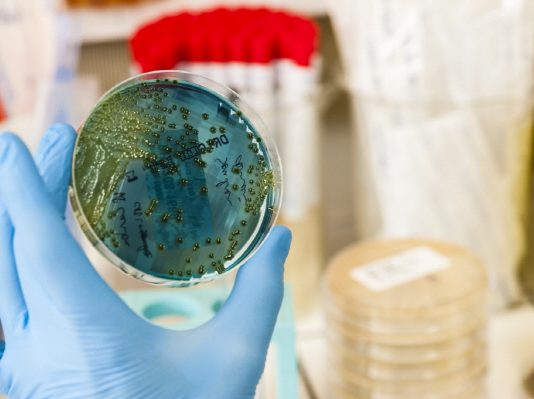
슈퍼 바이러스 잡고 내성없는 새로운 항생제 개발

KAIST 생명과학과 서성배 교수와 뉴욕대학교(NYU) 오양균 박사 공동연구팀이 초파리 모델 시스템을 이용해 뇌 속에 체내 혈당에 직접적인 기능을 하는 포도당 감지 신경세포를 발견하고 그 구체적인 원리를 밝혔다. 이번 연구는 초파리 뇌 속의 포도당 감지 신경세포가 인슐린 생산 조직 활성화, 글루카곤 생산 조직 활동 억제 등을 통해 체내 혈당 조절에 어떻게...
2019년 노벨 생리의학상을 수상한 연구가 27년 전엔 유명한 과학 저널 네이처(Nature)에서 게재를 거부했던 것으로 드러났다. 올해 노벨 생리의학상은 '인간의 세포가 변화하는 산소 가용성을 어떻게 감지하고 적응하는가'에 대한 연구 공로자인 윌리엄 케일린(William Kaelin Jr.) 하버드대 교수, 그레그 서멘자(Gregg Semenza) 존스홉킨스대 의대 교수, 피터 랫클리프(Peter Ratcliffe) 옥스퍼드대 의대 교수가 공동 수상했다. 스웨덴 카롤린스카...
올해 노벨 생리의학상은 미국의 윌리엄 캐얼린과 그레그 서멘자, 영국의 피터 랫클리프 등 3명이 공동 수상했다. 스웨덴 카롤린스카 연구소 노벨위원회는 7일(현지시간) 윌리엄 케얼린 하버드대 교수, 그레그 서멘자 존스홉킨스대 의대 교수, 피터 랫클리프 옥스퍼드대 의대 교수가2019년 노벨 생리의학상 공동수상자로 선정됐다고 발표했다.노벨위원회는 세포가 어떻게 변화하는 산소 가용성을 감지하고 적응하는지 발견한 공로로 이들 세...
국내 과학자들이 연구팀이 인체 조직의 3차원 게놈 지도를 해독하는 데 성공했다. KAIST 생명과학과 정인경 교수와 미국 루드윅 암 연구소(Ludwig Institute of Cancer Research) 빙 렌 (Bing Ren) 교수 공동 연구팀이 인체 조직의 3차원 게놈 지도를 해독하는 데 성공했다고 24일 밝혔다. 3차원 게놈 구조는 멀리 떨어져 있는 두 게놈 지역이 공간상에 인접할...
국내 연구진이 혈액이나 땀, 침 한 방울로 초기 잠복상태 치매까지 판별해 내는 조기진단키트를 개발했다.경상대학교 김명옥 교수 연구팀이 치매를 손쉽게 조기 진단할 수 있는 새로운 개념의 진단키트를 개발했다.연구 성과는 국제적인 저널인 네이처 자매지인 사이언티픽 리포터(Scientific Reports)에 논문명 ‘형광 나노 입자 이미징을 이용한 알츠하이머 병의 조기 진단을 위한 새로운 키트(A novel kit...
'치아' 표면층 에나멜(법랑질)이 녹아서 생기는 충치로 전 세계 사람들이 시달리고 있다. 에나멜이 손상되면 신체 자연치유는 불가능하다. 따라서 법랑질의 관리와 치료는 치의학의 주된 관심사 가운데 하나다.중국 저장대학(Zhejiang University) 연구팀이 손상된 치아 '에나멜‘을 복구하는 기술을 개발했다.치아의 에나멜은 무기질과 미네랄로 구성된 조직으로 석회화 과정에 의해 형성된다. 에나멜 아세포라는 세포가 ‘에나멜 단백질’이라는 특수한...
올리브유에 함유된 올레산이 노화 방지 및 장수에 중요한 역할을 한다는 사실이 밝혀졌다.KAIST 생명과학과 이승재 교수 연구팀이 지방 대사, 특히 불포화 지방산의 대사가 저온 환경에 적응할 수 있도록 생체 내에서 변화하고, 생명체가 오래 살도록 하는 데에 필수적이라는 것을 밝혀냈다. 이번 연구결과는 저명 국제 학술지 ‘플로스 바이올로지(PLOS Biology)’ 8월 13일 자 온라인판에...
현대 인류는 아프리카를 기원으로 전 세계에 퍼졌다는 것이 정설이다. 인간이 아프리카에서 유라시아 대륙으로 퍼질 때쯤 이미 많은 장소에는 네안데르탈인과 데니 소바인이 인간보다 더 오래전부터 살고 있었다. 그 과정에서 호모 사피엔스가 약 2만 년 전에 멸종한 네안데르탈인 및 데니소바인과 섹스를 통해 DNA가 섞였다는 많은 연구 결과가 나오고 있다. 그런데 이번에는 네안데르탈인(Neanderthal man)과...
19세기 오스트리아의 유전학자이자 성직자인 그레고어 멘델(Gregor Mendel)은 완두콩 교배 실험을 통해 생물이 가지는 모양과 성질이 자손에게 유전하는 것을 발견했다. 그 이후 자손에게 선천적인 유전자만 물려주는 것으로 알려져 왔다. 하지만, 최근에는 부모의 스트레스와 기억 등 경험도 유전되고 있다는 실험 결과가 나오고 있다.다트머스 대학(Dartmouth College) 게이젤 의과대(Geisel School of Medicine) 연구팀이...
1928년 페니실린이 발견된 이후 항생제는 현대의학을 크게 발전시켰다. 하지만 최근에는 어떤 항생제를 써도 듣지 않는 항생제 내성을 가진 '슈퍼 바이러스(Super-Viruses)’가 탄생해 인류를 괴롭히고 있다. 그동안 많은 의학 연구자들이 슈퍼 바이러스에 대응책을 모색하고 있지만 뚜렷한 방법이 없었다.그런 가운데, 프랑스 렌 제1대학(University of Rennes 1) 연구팀이 항생제에 내성을 가진 바이러스에 대항하는...
국내 연구진이 피를 뽑거나 복잡한 과정을 거치지 않고 바이오 센서를 통해 혈액 속 질병을 진단할 수 있는 차세대 진단기술을 개발했다. 최헌진 연세대 교수팀이 혈액 속에 존재하는 ‘질병마커(질병 원인 물질)’를 실시간으로 감지하는 시스템을 개발했다. 연구 성과는 국제학술지 ‘나노 레터스(Nano Letters)’ 3월 12일에 논문명 ‘Real-Time Detection of Markers in Blood’으로 게재됐다. ▲...
위스콘신 매디슨대학 (University of Wisconsin-Madison) 재료공학 교수인 쉬동 왕(Xudong Wang)과 대학원생 광 야오(Guang Yao)는 배터리가 필요 없는 1cm 크기의 다이어트용 이식 장치 개발에 성공했다. 개발된 장치는 작은 동전 크기로 사람의 뱃속에 직접 이식해 사용된다. 이 장치에는 배터리를 탑재하고 있지 않기 때문에, 한번 설치되면 배터리를 교체할 필요가 없다. 그 대신 음식을 먹을 때 발생하는 위의 연동 움직임에 따라 '나노 발전기'가 전기 신호를 생성하고 위장과 뇌를 연결하는 미주 신경에 전달한다. 이 전기 신호가 뇌에 "배부르다"고 착각하게 만들어 다이어트할 수 있다.


























![[보고서] 딥씨크 출현과 한국 AI 미래전략](http://8www.itnews.or.kr/wp-content/uploads/2025/02/7-218x150.png)

![[2024 애플 동향] ③ 애플카 ‘프로젝트 타이탄’의 실패 원인](http://8www.itnews.or.kr/wp-content/uploads/2024/03/1-2-218x150.png)
![[2024 애플 동향] ② 애플카 ‘프로젝트 타이탄’ 10년간 의 여정](http://8www.itnews.or.kr/wp-content/uploads/2024/03/4-218x150.png)
![[2024 애플 동향] ① 애플 프로젝트 타이탄’ 종료](http://8www.itnews.or.kr/wp-content/uploads/2024/03/Midjourney-218x150.png)